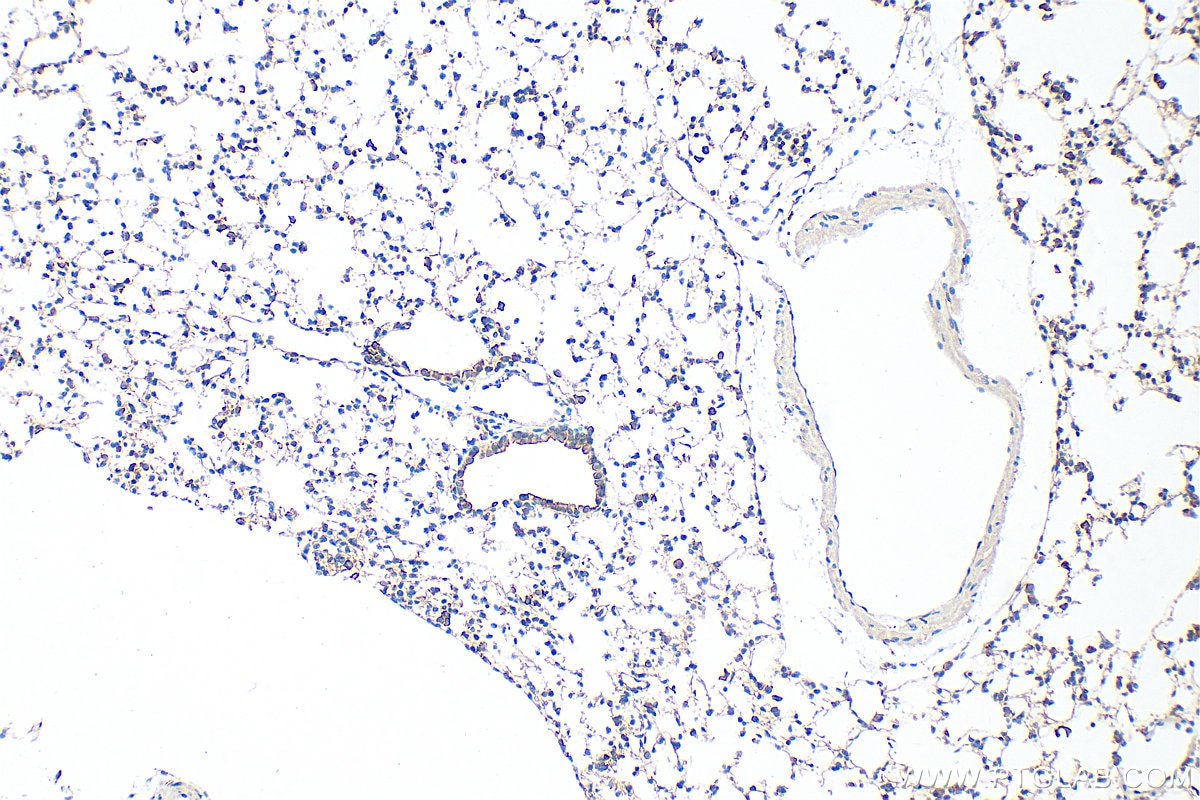
Immunohistochemical analysis of paraffin-embedded mouse lung tissue slide using 22167-1-AP (IQGAP1 antibody) at dilution of 1:1000 (under 10x lens). Heat mediated antigen retrieval with Tris-EDTA buffer (pH 9.0). Immunohistochemistry (IHC) staining of mouse lung tissue using IQGAP1 Polyclonal antibody (22167-1-AP)

Tested Applications
| Positive WB detected in | A549 cells, HeLa cells, SGC-7901 cells, HepG2 cells, NIH/3T3 cells |
| Positive IP detected in | HeLa cells |
| Positive IHC detected in | mouse kidney tissue, human breast cancer tissue, human colon tissue, mouse lung tissue Note: suggested antigen retrieval with TE buffer pH 9.0; (*) Alternatively, antigen retrieval may be performed with citrate buffer pH 6.0 |
| Positive IF/ICC detected in | MCF-7 cells, HeLa cells, A549 cells |
| Positive FC (Intra) detected in | HeLa cells |
Recommended dilution
| Application | Dilution |
|---|---|
| Western Blot (WB) | WB : 1:2000-1:10000 |
| Immunoprecipitation (IP) | IP : 0.5-4.0 ug for 1.0-3.0 mg of total protein lysate |
| Immunohistochemistry (IHC) | IHC : 1:500-1:2000 |
| Immunofluorescence (IF)/ICC | IF/ICC : 1:200-1:800 |
| Flow Cytometry (FC) (INTRA) | FC (INTRA) : 0.25 ug per 10^6 cells in a 100 µl suspension |
| It is recommended that this reagent should be titrated in each testing system to obtain optimal results. | |
| Sample-dependent, Check data in validation data gallery. | |
Published Applications
| KD/KO | See 4 publications below |
| WB | See 14 publications below |
| IHC | See 2 publications below |
| IF | See 1 publications below |
| IP | See 1 publications below |
Product Information
22167-1-AP targets IQGAP1 in WB, IHC, IF/ICC, FC (Intra), IP, ELISA applications and shows reactivity with human, mouse samples.
| Tested Reactivity | human, mouse |
| Cited Reactivity | human, mouse |
| Host / Isotype | Rabbit / IgG |
| Class | Polyclonal |
| Type | Antibody |
| Immunogen |
CatNo: Ag17821 Product name: Recombinant human IQGAP1 protein Source: e coli.-derived, PGEX-4T Tag: GST Domain: 478-827 aa of BC151834 Sequence: QLSSSVTGLTNIEEENCQRYLDELMKLKAQAHAENNEFITWNDIQACVDHVNLVVQEEHERILAIGLINEALDEGDAQKTLQALQIPAAKLEGVLAEVAQHYQDTLIRAKREKAQEIQDESAVLWLDEIQGGIWQSNKDTQEAQKFALGIFAINEAVESGDVGKTLSALRSPDVGLYGVIPECGETYHSDLAEAKKKKLAVGDNNSKWVKHWVKGGYYYYHNLETQEGGWDEPPNFVQNSMQLSREEIQSSISGVTAAYNREQLWLANEGLITRLQARCRGYLVRQEFRSRMNFLKKQIPAITCIQSQWRGYKQKKAYQDRLAYLRSHKDEVVKIQSLARMHQARKRYRD Predict reactive species |
| Full Name | IQ motif containing GTPase activating protein 1 |
| Calculated Molecular Weight | 189 kDa |
| Observed Molecular Weight | 190-195 kDa |
| GenBank Accession Number | BC151834 |
| Gene Symbol | IQGAP1 |
| Gene ID (NCBI) | 8826 |
| ENSEMBL Gene ID | ENSG00000140575 |
| RRID | AB_10949193 |
| Conjugate | Unconjugated |
| Form | Liquid |
| Purification Method | Antigen affinity purification |
| UNIPROT ID | P46940 |
| Storage Buffer | PBS with 0.02% sodium azide and 50% glycerol, pH 7.3. |
| Storage Conditions | Store at -20°C. Stable for one year after shipment. Aliquoting is unnecessary for -20oC storage. 20ul sizes contain 0.1% BSA. |
Background Information
IQGAP1 is a member of a family of scaffolding proteins that interact with signaling and structural molecules. It localizes to sites of cell-cell contact in epithelial cells and regulates distinct cellular processes including cell adhesion, cell migration, extracellular signals through interacting with numerous protein. Multiple studies have shown that IQGAP1 is up-regulated in many human malignancies, such as lung cancer, ovarian cancer, colon cancer, breast cancer, melanoma and HCC. And IQGAP1 plays a critical role in cancer cell invasion.
Protocols
| Product Specific Protocols | |
|---|---|
| FC protocol for IQGAP1 antibody 22167-1-AP | Download protocol |
| IF protocol for IQGAP1 antibody 22167-1-AP | Download protocol |
| IHC protocol for IQGAP1 antibody 22167-1-AP | Download protocol |
| IP protocol for IQGAP1 antibody 22167-1-AP | Download protocol |
| WB protocol for IQGAP1 antibody 22167-1-AP | Download protocol |
| Standard Protocols | |
|---|---|
| Click here to view our Standard Protocols |
Publications
| Species | Application | Title |
|---|---|---|
Nat Commun Targeting NRAS via miR-1304-5p or farnesyltransferase inhibition confers sensitivity to ALK inhibitors in ALK-mutant neuroblastoma | ||
Cancer Commun (Lond) Glutamine metabolic microenvironment drives M2 macrophage polarization to mediate trastuzumab resistance in HER2-positive gastric cancer
| ||
Theranostics Anti-allergic drug azelastine suppresses colon tumorigenesis by directly targeting ARF1 to inhibit IQGAP1-ERK-Drp1-mediated mitochondrial fission. | ||
Oncogene The scaffold protein IQGAP1 links heat-induced stress signals to alternative splicing regulation in gastric cancer cells.
| ||
Oncotarget Diet-induced hypercholesterolemia promotes androgen-independent prostate cancer metastasis via IQGAP1 and caveolin-1. | ||
Front Cell Infect Microbiol IQGAP1 Mediates Hcp1-Promoted Escherichia coli Meningitis by Stimulating the MAPK Pathway.
|
Reviews
The reviews below have been submitted by verified Proteintech customers who received an incentive for providing their feedback.
FH JIN-FENG (Verified Customer) (10-01-2025) | I used the IQGAP1 antibody to screen my CRISPR-generated cells. It produced a highly specific signal, which gave me confidence throughout the screening process.
![]() |
FH Joleen (Verified Customer) (06-16-2019) | The antibody recognizes IQGAP (top band) but also another band at a lower molecular weight.
![]() |
FH Chun-Chih (Verified Customer) (01-31-2019) | Works well in IP at recommended conc. Clear and strong band, 1mg protein lysate per condition.
|